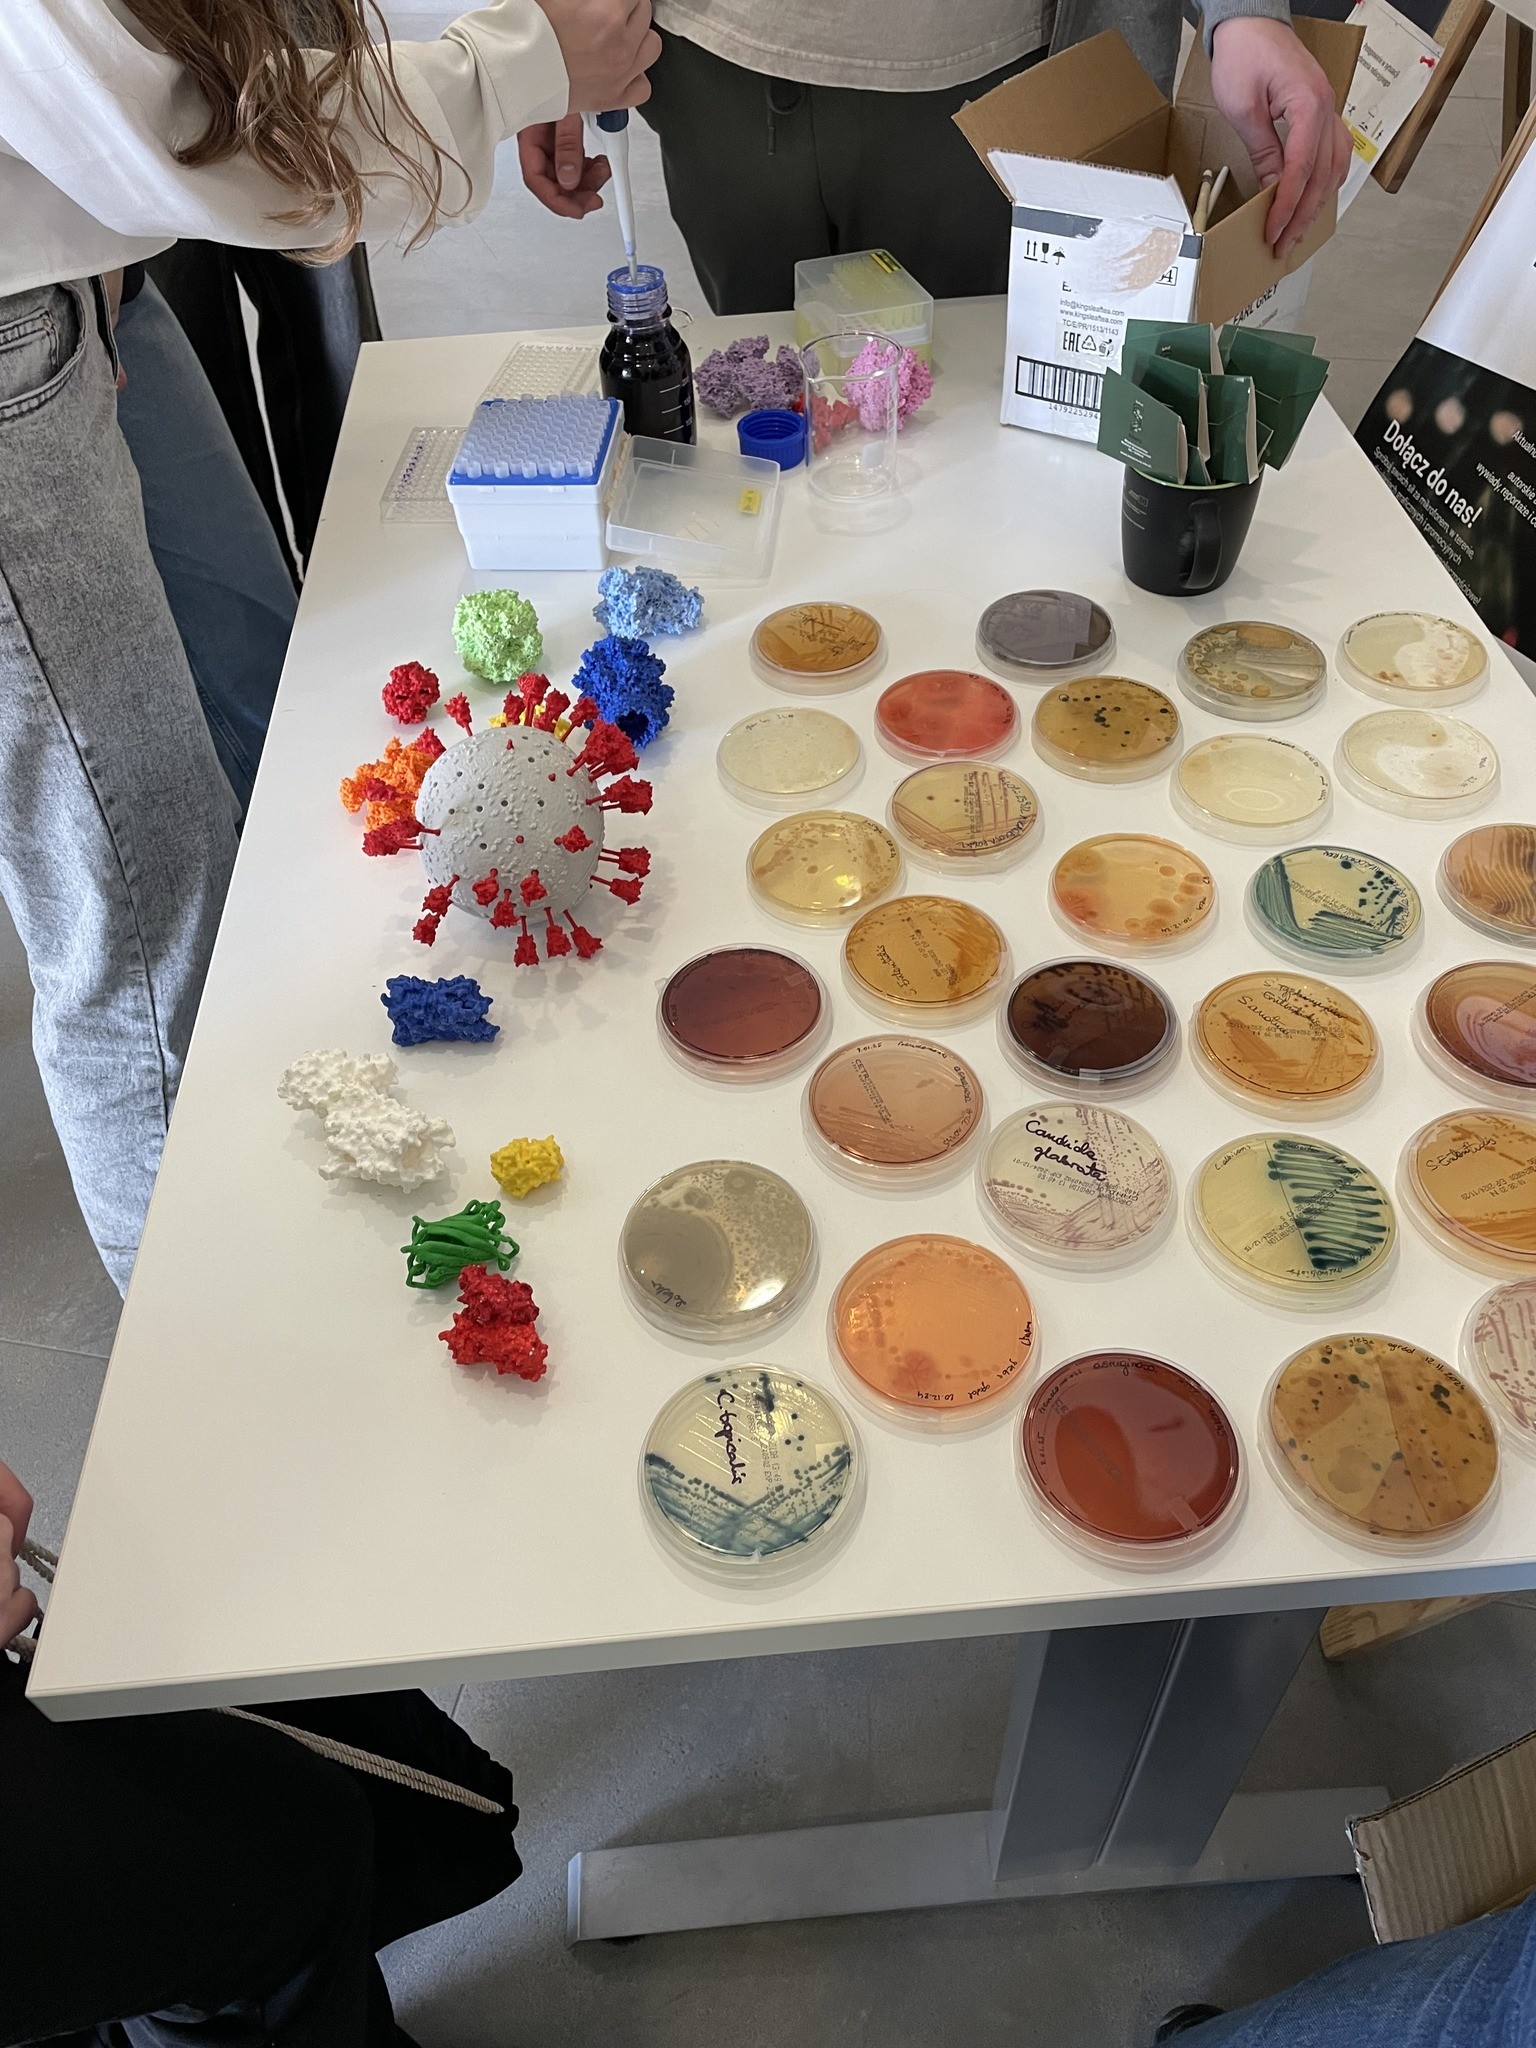

20 marca na Międzyuczelnianym Wydziale Biotechnologii Uniwersytetu Gdańskiego odbył się finał Konkursu Wiedzy Biotechnologicznej. Uczestniczyły w nim Jagoda Chabowska z 3C i Zuzanna Kowalska z 2C przygotowane przez panią Małgorzatę Turyn. Tegoroczna edycja dotyczyła zielonej biotechnologii. Uczestnicy poza testem mieli okazję wysłuchać wykładu popularnonaukowego na temat mikrobiomu człowieka oraz zwiedzić budynek wydziału i dowiedzieć się jak wyglądają studia na kierunku biotechnologia.



